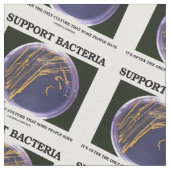
Tissu Support Bacteria (Fermer)

Cartes de visite juridique et finance
Cartes de visite marketing et com
Cartes de visite sport et fitness
Cartes de visite beauté et soins
Cartes de visite BTP et artisanat
Cartes de visite restauration
Cartes de visite photographie
Cartes de visite santé et bien-être
A propos de Tissus
Vendu (e) par
À propos de ce design
Tissu Support Bacteria
Concevez et créez avec une dose d'attitude microbiologique irréfléchie avec ce tissu avec une plaque d'agar avec des colonies bactériennes, avec le dicton scientifique suivant : "Soutenez les bactéries - C'est souvent la seule culture que certaines personnes ont". Pas besoin d'être un anthropologue biologique pour en profiter !
Traduction automatique
Avis des clients
5.0 sur 5 étoiles4 Nombres de Commentaires
4 Commentaires
Avis sur des produits similaires
5.0 sur 5 étoiles
5 sur 5 étoilesPar Bernadette S.6 décembre 2020 • Achat sécurisé
Tissu, Coton peigné (Largeur: 142,24 cm)
Programme d'évaluation de Zazzle
Tissus parfait je recommande se site. Couleurs impeccable suis très satisfaite.
5.0 sur 5 étoiles
5 sur 5 étoilesPar C.4 juillet 2020 • Achat sécurisé
Tissu, Coton Pima(Largeur : 137,16 cm)
Programme d'évaluation de Zazzle
Superbe qualité merci. Superbe qualité impeccable merci
5.0 sur 5 étoiles
5 sur 5 étoilesPar C.4 juillet 2020 • Achat sécurisé
Tissu, Coton Pima(Largeur : 137,16 cm)
Programme d'évaluation de Zazzle
Magnifique j adore!!!! Impression parfaite merci
Tags
Autres infos
Identifiant du produit : 256068258719252790
Fabriqué le 04/10/2015 23:28
Évalué G